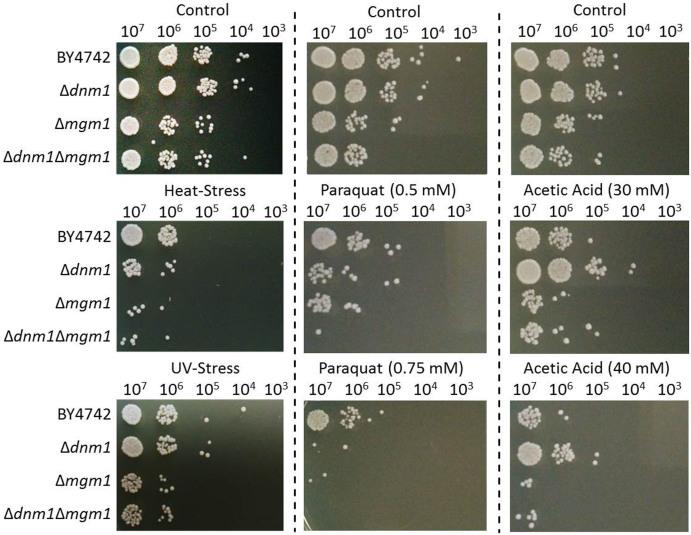
https://cdn.ncbi.nlm.nih.gov/pmc/blobs/579e/4298727/c56669d04274/srep07885-f3.jpg

线粒体分裂和融合的同时受损会降低线粒体自噬并缩短复制寿命。
Simultaneous impairment of mitochondrial fission and fusion reduces mitophagy and shortens replicative lifespan.
作者信息
Bernhardt Dominik, Müller Matthias, Reichert Andreas S, Osiewacz Heinz D
机构信息
Goethe University, Faculty for Biosciences &Cluster of Excellence, 'Macromolecular Complexes' Frankfurt, Institute of Molecular Biosciences, Max-von-Laue-Str. 9, 60438 Frankfurt, Germany.
Mitochondrial Biology, Buchmann Institute for Molecular Life Sciences &Zentrum für Molekulare Medizin, Goethe University, Max-von-Laue-Str. 15, 60438 Frankfurt am Main, Germany.
出版信息
Sci Rep. 2015 Jan 20;5:7885. doi: 10.1038/srep07885.
Aging of biological systems is accompanied by degeneration of mitochondrial functions. Different pathways are active to counteract the processes which lead to mitochondrial dysfunction. Mitochondrial dynamics, the fission and fusion of mitochondria, is one of these quality control pathways. Mitophagy, the controlled degradation of mitochondria, is another one. Here we show that these pathways are linked. A double deletion mutant of Saccharomyces cerevisiae in which two essential components of the fission and fusion machinery, Dnm1 and Mgm1, are simultaneously ablated, contain wild-type like filamentous mitochondria, but are characterized by impaired respiration, an increased sensitivity to different stressors, increased mitochondrial protein carbonylation, and a decrease in mitophagy and replicative lifespan. These data show that a balanced mitochondrial dynamics and not a filamentous mitochondrial morphotype per se is the key for a long lifespan and demonstrate a cross-talk between two different mitochondrial quality control pathways.
生物系统的衰老伴随着线粒体功能的退化。不同的途径会被激活以对抗导致线粒体功能障碍的过程。线粒体动力学,即线粒体的分裂和融合,是这些质量控制途径之一。线粒体自噬,即线粒体的可控降解,是另一种途径。在这里,我们表明这些途径是相互关联的。酿酒酵母的双缺失突变体,其中分裂和融合机制的两个关键成分Dnm1和Mgm1同时缺失,含有野生型丝状线粒体,但具有呼吸受损、对不同应激源的敏感性增加、线粒体蛋白羰基化增加以及线粒体自噬和复制寿命降低的特征。这些数据表明,平衡的线粒体动力学而非丝状线粒体形态本身是长寿的关键,并证明了两种不同线粒体质量控制途径之间的相互作用。